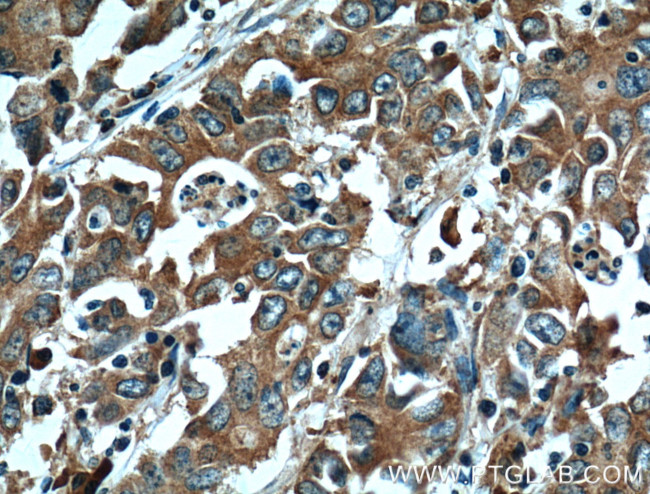
EPHA1 Antibody in Immunohistochemistry (Paraffin) (IHC (P))
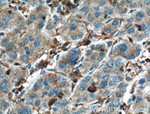
EPHA1 Antibody in Immunohistochemistry (Paraffin) (IHC (P))

Search
Proteintech
EPHA1 Monoclonal Antibody (1B7C3)
{{$productOrderCtrl.translations['antibody.pdp.commerceCard.promotion.promotions']}}
{{$productOrderCtrl.translations['antibody.pdp.commerceCard.promotion.viewpromo']}}
{{$productOrderCtrl.translations['antibody.pdp.commerceCard.promotion.promocode']}}: {{promo.promoCode}} {{promo.promoTitle}} {{promo.promoDescription}}. {{$productOrderCtrl.translations['antibody.pdp.commerceCard.promotion.learnmore']}}
产品信息
60155-2-IG
种属反应
宿主/亚型
分类
类型
克隆号
抗原
偶联物
形式
浓度
规格
纯化类型
保存液
内含物
保存条件
运输条件
靶标信息
EphA1 belongs to the ephrin receptor subfamily of the protein-tyrosine kinase family. EPH and EPH-related receptors have been implicated in mediating developmental events, particularly in the nervous system. Receptors in the EPH subfamily typically have a single kinase domain and an extracellular region containing a Cys-rich domain and 2 fibronectin type III repeats. The ephrin receptors are divided into 2 groups based on the similarity of their extracellular domain sequences and their affinities for binding ephrin-A and ephrin-B ligands. EphA1 is expressed in some human cancer cell lines and has been implicated in carcinogenesis.
仅用于科研。不用于诊断过程。未经明确授权不得转售。
篇参考文献 (0)
生物信息学
蛋白别名: EPH tyrosine kinase; EPH tyrosine kinase 1; Ephrin type-A receptor 1; erythropoietin-producing hepatoma amplified sequence; Erythropoietin-producing hepatoma receptor; hEpha1; MGC163163; oncogene EPH; tyrosine kinase receptor precursor (put.); putative; Tyrosine-protein kinase receptor EPH; unnamed protein product
基因别名: EPH; EPHA1; EPHT; EPHT1
UniProt ID: (Human) P21709
Entrez Gene ID: (Human) 2041